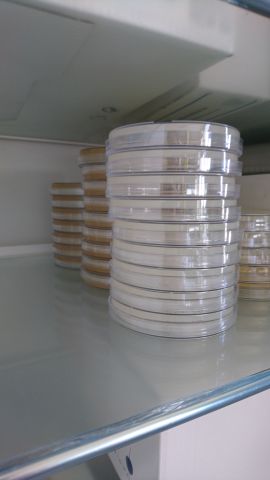
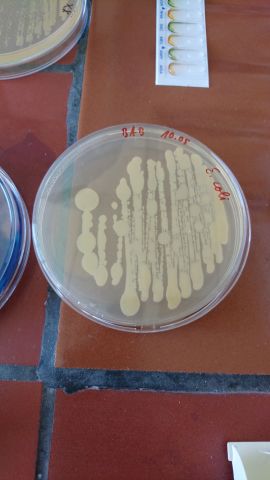

Besuch aus Aserbaidschan
Am 14.05.2019 hatten wir Besuch aus unserer Partnerstadt Sumgait (Nähe Baku), mit der eine langjährige Kooperation mit den Wirtschaftsbetrieben Ludwigshafen (Abwasserkontrolle) besteht. Unsere Gäste waren neugierig zu erfahren, wie in Deutschland die Trinkwasserkontrolle nach TVO durchgeführt wird. Hierzu stellte sich unser Kollege Dr. Josef Breidenbach (Fachbereich Mikrobiologie) zur Verfügung, unseren Gästen einen kurzen Einblick in die Arbeitsweisen nach der aktuell geltenden DIN-Vorschrift zu geben.
Nach einer theoretischen Einführung über den Fäkalindikator Escherichia coli und den zu erwartenden Reaktionen mit dem Nährmedium, ging es ins Labor.